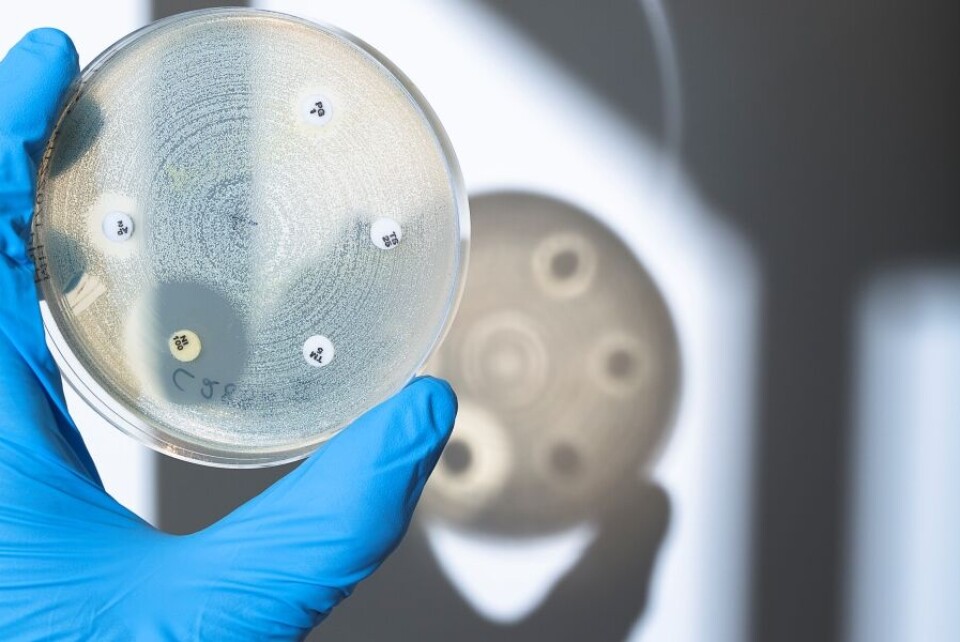

Fra redaksjonen
Vi må handle NÅ!
Hissige bakterier, medisiner som ikke virker, død og fordervelse.Er det framtida?
Begrepet «den post-antibiotiske æra dukker opp stadig oftere og kan skremme vannet av noen og enhver. For hva skjer hvis det «uskyldige» såret aldri gror, hvis urinveisinfeksjonen ikke leges – og for ikke å snakke om; hvis vi får tuberkulose?
Vi er vant til å få medisiner som virker. Vi forventer det, ja, vi nærmest krever det.
Men kanskje ikke så mye lenger? Hvis antibiotikaresistens blir normaltilstanden er det i tilfelle et kjempeproblem - for hele verden!
Det er derfor ikke overraskende at IFBLS (bioingeniørenes verdensorganisasjon) har valgt nettopp antibiotikaresistens som tema for bioingeniørdagen i år og neste år. Det er knapt en yrkesgruppe som er viktigere i arbeidet med å påvise antibiotikaresistens enn bioingeniører. Men hva kan bioingeniører gjøre for å bekjempe resistens?
Kanskje finnes det veier rundt resistensproblemene? Nye, smarte løsninger?
Fagartikkelen i Bioingeniørens marsutgave sier noe om det. Anita Løvås Brekken, bioingeniør i Stavanger, har undersøkt hva de mikrobiologiske laboratoriene kan bidra med. Svarene hun fant peker på noen tiltak som bør være fullt gjennomførbare. Som raskere prøvehåndtering, lengre åpningstider på laboratoriene og større kursbudsjetter (bioingeniørene må kjenne igjen en farlig resistens når de ser den).
Men verden trenger også nye medisiner. Vi har intervjuet noen av forskerne som kanskje kan bidra til det. Det er nesten 30 år siden det siste nye antibiotikumet kom, og behovet for nye er åpenbart. Kanskje finnes det veier rundt resistensproblemene? Nye, smarte løsninger?
Hvis leger, pasienter, myndigheter, forskere og bioingeniører setter alle kluter til, finner vi kanskje veien ut av dette uføret vi selv har skapt.
Men vi må handle nå! Forhåpentligvis er det ennå tid.